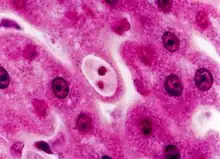

Adeleorina
| Adeleorina | |
|---|---|
| |
| Cyst of an unidentified haemogregarine in the liver of a bat | |
| Scientific classification | |
| Domain: | Eukaryota |
| Clade: | Diaphoretickes |
| Clade: | SAR |
| Clade: | Alveolata |
| Phylum: | Apicomplexa |
| Class: | Conoidasida |
| Order: | Eucoccidiorida |
| Suborder: | Adeleorina |
| Families | |
|
Adeleidae | |
Adeleorina is a suborder of parasites in the phylum Apicomplexa.[1]
History
Léger proposed this taxon in 1911. The first species identified was Dactylosoma ranarum by Lankester (1871) in a frog in Europe. It was initially called Undulina ranarum, but this was changed in 1882 to Drepanidium ranarum. This species was subsequently moved to the genus Dactylosoma.
Canine hepatozoonosis was first described in India in 1905 by James. The organism was named Leukocytozoon canis. The vector was identified in 1907 by Christopher to be the brown dog tick (Rhipicephalus sanguineus). The genus Hepatozoon was created by Miller in 1908 for a parasite of the white rat (Rattus norvegicus) that underwent merogony in the liver and sporogony in the mite Laelap echidinus. Ledger initially placed this genus in the family Haemogregarinidae, but Wenyon subsequently removed it and placed it in the newly created taxon Hepatozoidae in 1926.
Life cycle
All species in this suborder use the syzygy method of gamete formation. This involves the association of often motile gamonts prior to the formation of functional gametes and fertilization.
Their life cycles tend to be complex, involving at least one (and often several) asexual cycles of merogony followed by gametogony, syngamy and sporogony. In many species of the group, the meronts and merozoites have morphologically distinct types: one type of meront produces large merozoites which initiate a further round of merogonic replication; a second produces smaller merozoites which are the progenitors of the gamonts. Microgamonts produce usually only one to four microgametes. Other characteristic features include the absence of endodyogeny and the enclosure of sporozoites in a sporocyst.
In haemogregarines with heteroxenous species, conjugation of gamonts and subsequent sporogony usually occurs within an invertebrate (definitive host), which also serves as the vector. Merogonial division usually takes place in the parenchymatous organs of the vertebrate host. This is followed by the formation of infective gametocytes in the erythrocytes. In the genus Hepatozoon, gametocytes are also formed in the leukocytes.
The haemogregarines use two modes of transmission:
- Inoculation — the infectious sporozoites enter the vertebrate host during blood-feeding of the vector (Dactylosoma, Haemogregarina)
- Ingestion — the parasite is transmitted by the ingestion of the infected invertebrate host by the vertebrate host. The mode of transmission may even involve a paratenic host. The next definitive host in the life cycle is infected exclusively through blood feeding. Examples include the genera Karyolysus, Hemolivia and Hepatozoon.
Taxonomy
Adeleorina has about 500 species, which have been organised into seven families and 19 genera. The families have been divided into two groups:
- Adelines — monoxenous coccidians of invertebrates — Adeleidae and Legerellidae
- Haemogregarines — heteroxenous coccidians cycling between blood-sucking invertebrates (definitive hosts) and various vertebrates (intermediate hosts) — Dactylosomatidae, Haemogregarinidae, Hepatozoidae and Karyolysidae
One exception to this classification is known: Klossiella (family Klossiellidae) is a monoxenous coccidium of mammals and reptiles.
The taxonomy is this group may be incorrect as the Hepatozoidae appear to be paraphyletic.[2] The genus Hemolivia appears to lie within the genus Hepatozoon.[3] The genus Hepatozoon appears to have two subgenera with one in the carnivorous mammals and the other in lower vertebrates and rodents.[4]
Families and genera
The families in this suborder are:
- Family Adeleidae Mesnil, 1903
- Genera:
- Chagasella Machado in 1911
- Ganapatiella Kalavati, 1977
- Gibbsia Levine, 1986
- Klossia Schneiderin, 1875
- Orcheobius Schuberg & Kunze, 1906
- Rasajeyna Beesley, 1977
- Subfamily Ithaniinae
- Genera:
- Family Dactylosomatidae Jakowska & Nigrelli, 1955
- Genera:
- Babesiosoma Jakowska & Nigrelli, 1956
- Dactylosoma Labbé, 1894 [5]
- Genera:
- Family Haemogregarinidae Neveu-Lemaire, 1901
- Genera:
- Cyrilia Lainson, 1981
- Desseria Siddall, 1995
- Haemogregarina Danilewsky, 1885
- Genera:
- Family Hepatozoidae Wenyon, 1926
- Genera:
- Hepatozoon Miller, 1908
- Genera:
- Family Karyolysidae Wenyon, 1926
- Genera:
- Karyolysus Labbé, 1894
- Hemolivia Petit et al, 1990
- Genera:
- Family Klossiellidae Smith & Johnson, 1902
- Genera:
- Family Legerellidae Minchin, 1903
- Genera:
- Legerella Mesnil, 1900
- Genera:
Notes
Karyolysus infects lizards (Lacerta) and possibly scincids. Haemogregarina infects turtles and leeches. Species of the genus Desseria infect fish and lack erythrocytic merogony. The genera in the subfamily Ithaniinae share a number of morphological features and infect the digestive tract of insects.
DNA studies suggest Hemolivia may lie within the Hepatozoon clade.[3] If this can be confirmed, the taxonomy of this group will need revision. A study of the 18s rRNA gene suggests that there may be some overlap between Karyolysus and Hepatozoon.[6]
Karadjian, Chavatte and Landau revised the Adeleidae in 2015,[7] performed a molecular analysis and proposed a new classification in four 'types' based on their biology, as follows:
- Type I, Hepatozoon Miller, 1908, with type species H. perniciosum Miller, 1908
- Type II, Karyolysus Labbé, 1894, with type species K. lacertae (Danilewsky, 1886) Reichenow, 1913
- Type III Hemolivia Petit et al., 1990, with type species H. stellata Petit et al., 1990
- Type IV: Bartazoon Karadjian, Chavatte and Landau, 2015, with type species B. breinli (Mackerras, 1960).[7]
References
- ↑ "Adeleorina". NCBI Taxonomy Browser. 75740.
- ↑ Mathew JS, Van Den Bussche RA, Ewing SA, Malayer JR, Latha BR, Panciera RJ (April 2000). "Phylogenetic relationships of Hepatozoon (Apicomplexa: Adeleorina) based on molecular, morphologic, and life-cycle characters". J. Parasitol. 86 (2): 366–72. doi:10.1645/0022-3395(2000)086[0366:PROHAA]2.0.CO;2. PMID 10780559. S2CID 24122100.
- 1 2 Barta JR, Ogedengbe JD, Martin DS, Smith TG (2012). "Phylogenetic position of the adeleorinid coccidia (Myzozoa, Apicomplexa, Coccidia, Eucoccidiorida, Adeleorina) inferred using 18S rDNA sequences". J. Eukaryot. Microbiol. 59 (2): 171–80. doi:10.1111/j.1550-7408.2011.00607.x. PMID 22313415. S2CID 205760200.
- ↑ Criado-Fornelio A, Ruas JL, Casado N, et al. (February 2006). "New molecular data on mammalian Hepatozoon species (Apicomplexa: Adeleorina) from Brazil and Spain". J. Parasitol. 92 (1): 93–9. doi:10.1645/GE-464R.1. PMID 16629322. S2CID 6713713.
- ↑ Úngari, Letícia Pereira; Netherlands, Edward Charles; Quagliatto Santos, André Luiz; Alcantara, Edna Paulino de; Emmerich, Enzo; da Silva, Reinaldo José; O’Dwyer, Lucia Helena (2020). "A new species, Dactylosoma piperis n. sp. (Apicomplexa, Dactylosomatidae), from the pepper frog Leptodactylus labyrinthicus (Anura, Leptodactylidae) from Mato Grosso State, Brazil". Parasite. 27: 73. doi:10.1051/parasite/2020070. ISSN 1776-1042. PMC 7746082. PMID 33332263.

- ↑ Haklová-Kočíková B, Hižňanová A, Majláth I, Račka K, Harris DJ, Földvári G, Tryjanowski P, Kokošová N, Malčeková B, Majláthová V (2014). "Morphological and molecular characterization of Karyolysus--a neglected but common parasite infecting some European lizards". Parasit Vectors. 7: 555. doi:10.1186/s13071-014-0555-x. PMC 4298996. PMID 25492802.
- 1 2 Karadjian, Grégory; Chavatte, Jean-Marc; Landau, Irène (2015). "Systematic revision of the adeleid haemogregarines, with creation of Bartazoon n. g., reassignment of Hepatozoon argantis Garnham, 1954 to Hemolivia, and molecular data on Hemolivia stellata". Parasite. 22: 31. doi:10.1051/parasite/2015031. ISSN 1776-1042. PMC 4639712. PMID 26551414.
